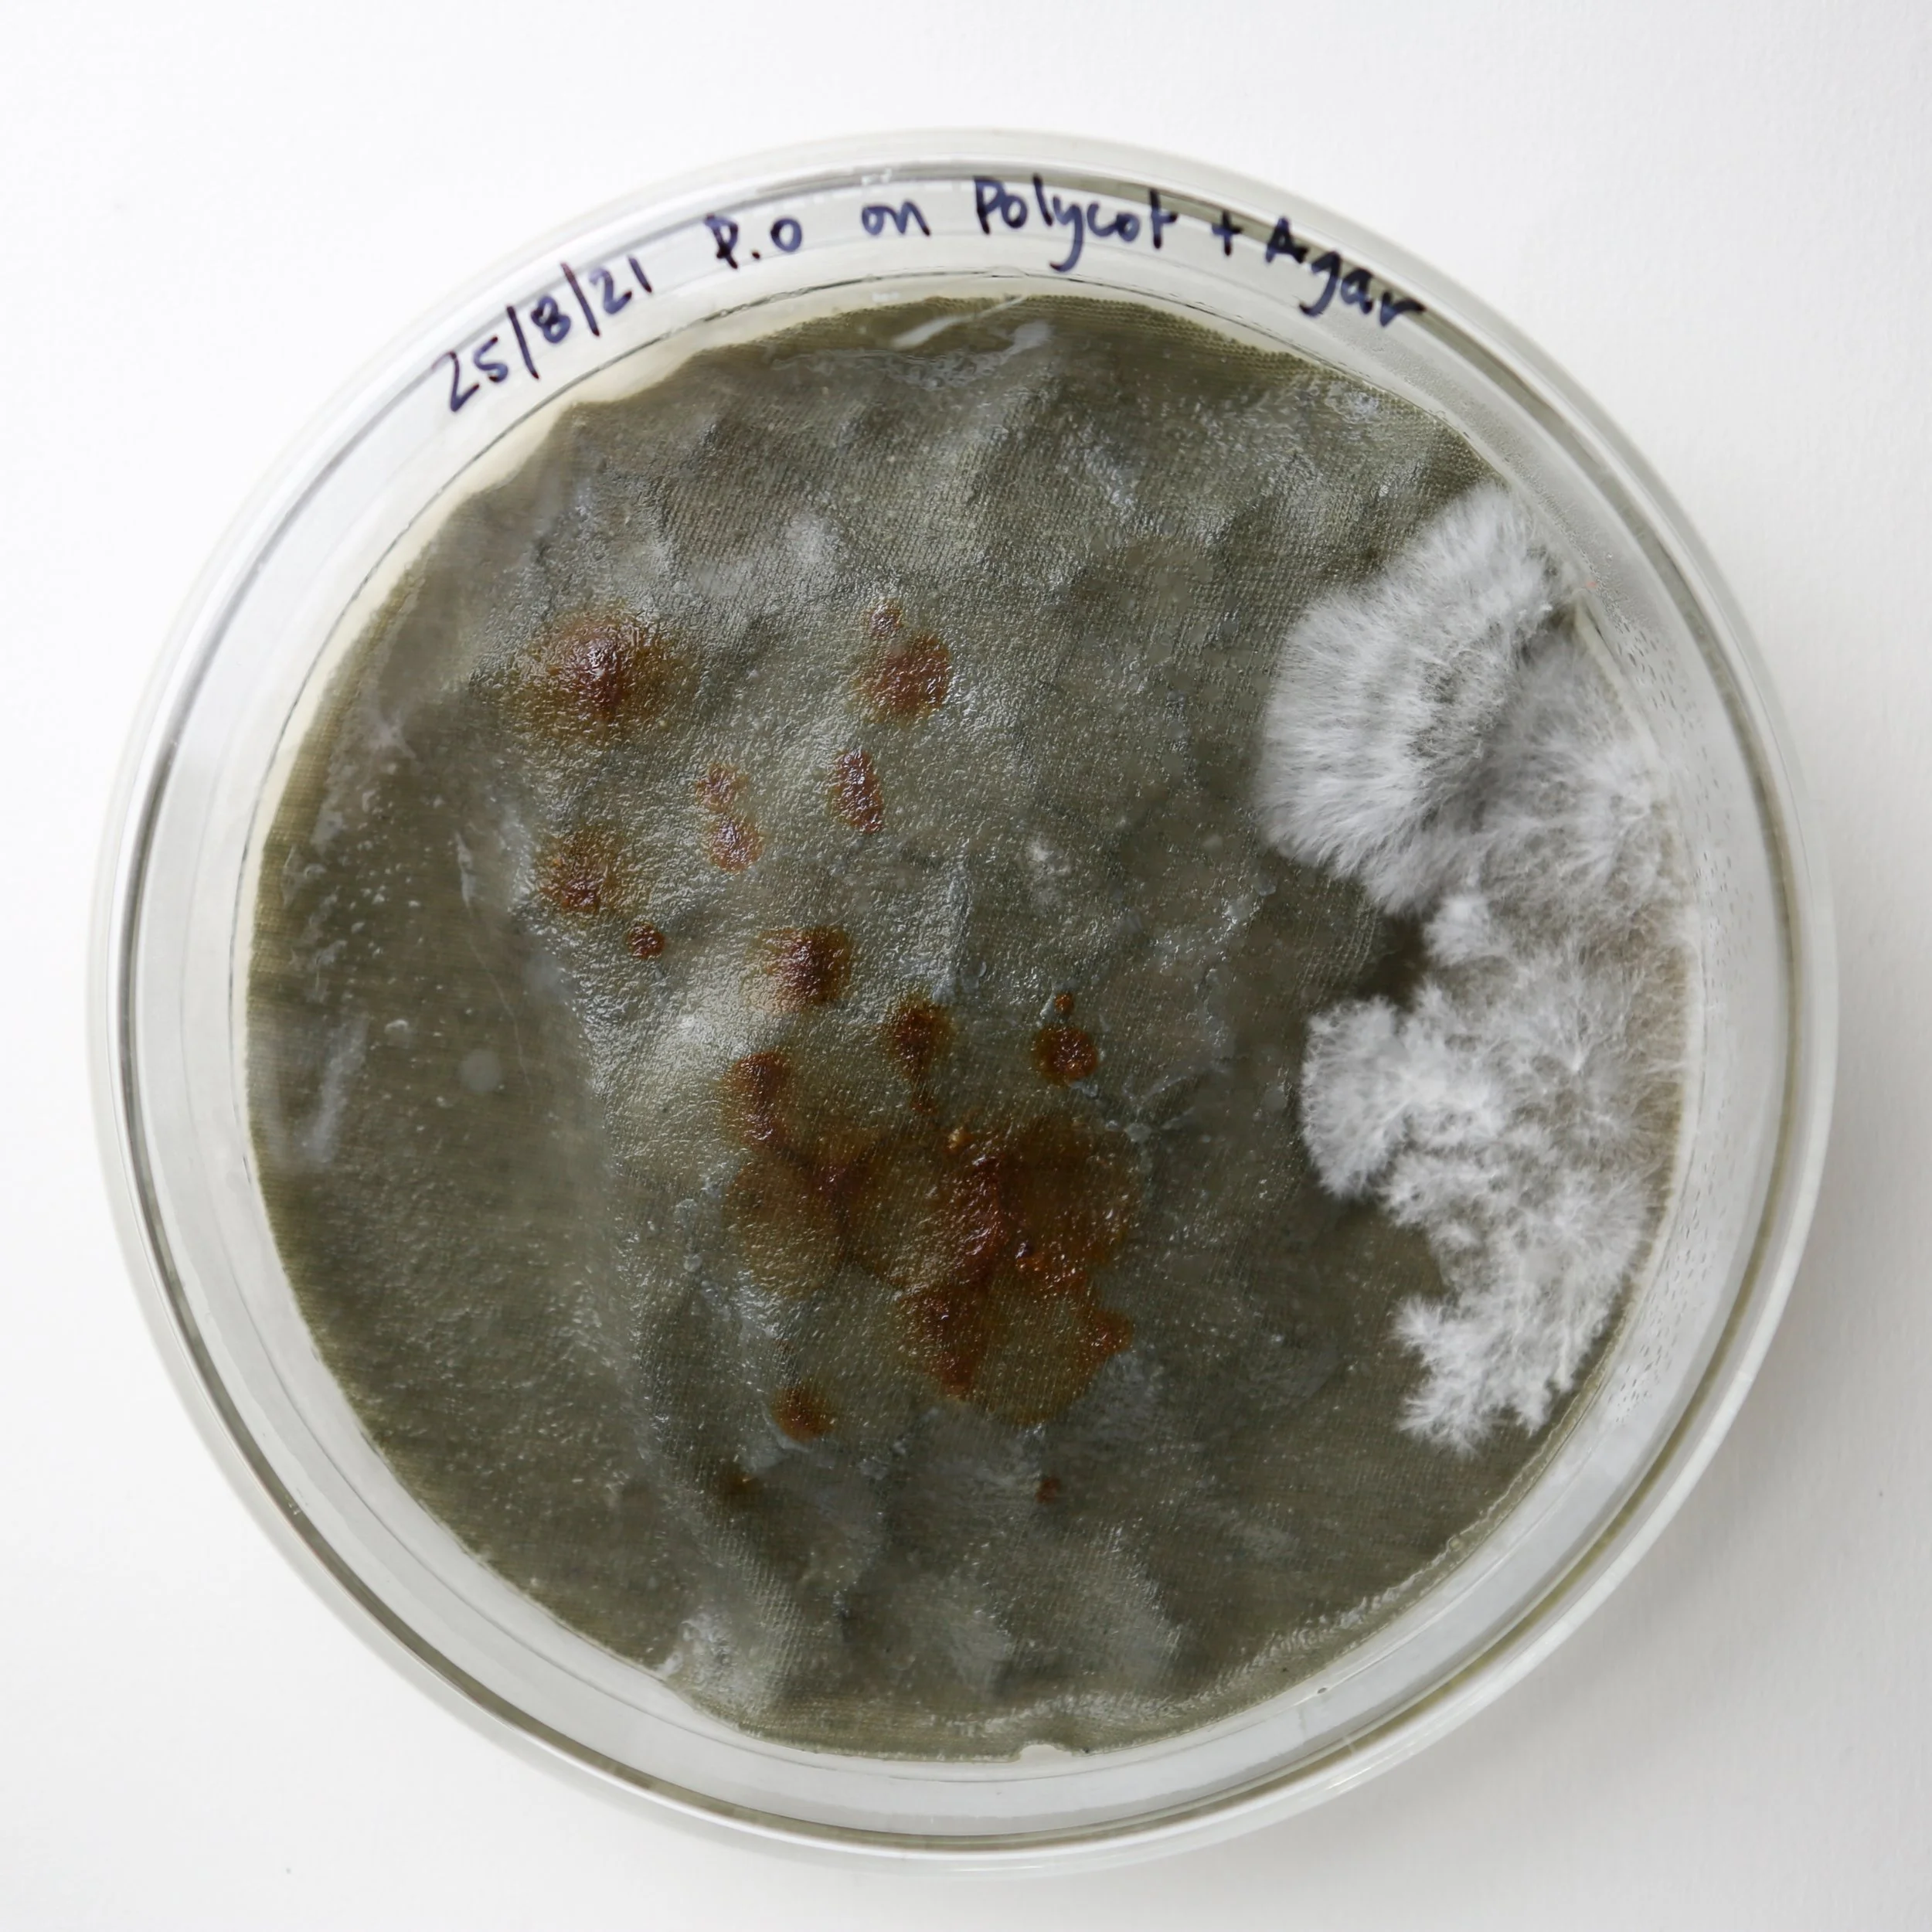

The Repairium is a testing-ground for iterative processes of repairing materials in collaboration with mushroom mycelium. The large custom made hand-blown irregular glass sphere, has been cut in two to allow materials to enter the micro-biosphere. The top half has a small opening to insert a filter and allow for the exchange of air, while the bottom half is flattened to allow for the object to rest on a table. The Repairium has been designed to operate as a site of experimentation, where textiles in need of repair may be introduced to the gustatory preferences of mushroom mycelium.
In developing the work, I produced a significant body of experiments in large glass petri dishes (see above), exploring a range of ‘ingredients’ and using culinary techniques that was more akin to cooking and ‘preparing a meal’ than what is usually thought of as a textile practice. In her book ‘Eating in Theory’, Anne Marie Mol makes the case for eating as a dispersed and relational process, stating “in eating, then, I am a semipermeable, internally differentiated being, getting enmeshed in intricate ways with pieces of my surroundings” (2021 p.36). The project and concomitant experiments looked to explore the importance of dietary variation through a range of nutrients, fibre types and intensities that in and of themselves may have repairative capacities for mycelial networks and their entangled metabolic web of biological processes.
Various iterations of this work have been exhibited in ‘Biomateriality’ at the Delmar Gallery in Sydney in May 2022, and during ‘Textiles Week’ at UNSW Art & Design Sydney, AD Space in June 2022.
Photography: Alia Parker and Silversalt